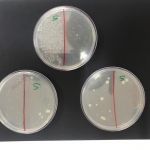

A IMPORTÂNCIA DE FAZER A HIGIENE BUCAL E MANTER AS MÃOS LIMPAS
Todas as formas de vida, até mesmo as microscópicas merecem nossa atenção!
Bactérias são encontradas em todos os lugares, no ar, na água, nos brinquedos e no nosso corpo. Existem bactérias do bem e do mal; estas últimas podem nos deixar doentes.
Para mostrar a quantidade de bactérias que as pessoas carregam nas mãos e na boca, a bióloga MICHELYNE SIDNEY CASTRO FARIA (Michelyne Faria) propôs aos alunos do Infantil V fazer um experimento. Coletou material obtido na mucosa da boca e na pele das mãos das crianças. Cada material coletado foi colocado numa placa própria para desenvolver a cultura de microrganismos.
Durante uma semana, as crianças observaram o crescimento diferenciado das bactérias nas duas placas.
Observando o resultado do experimento, os alunos concluíram que, para se protegerem de doenças, devem sempre lavar as mãos e fazer uma higiene bucal cuidadosa.